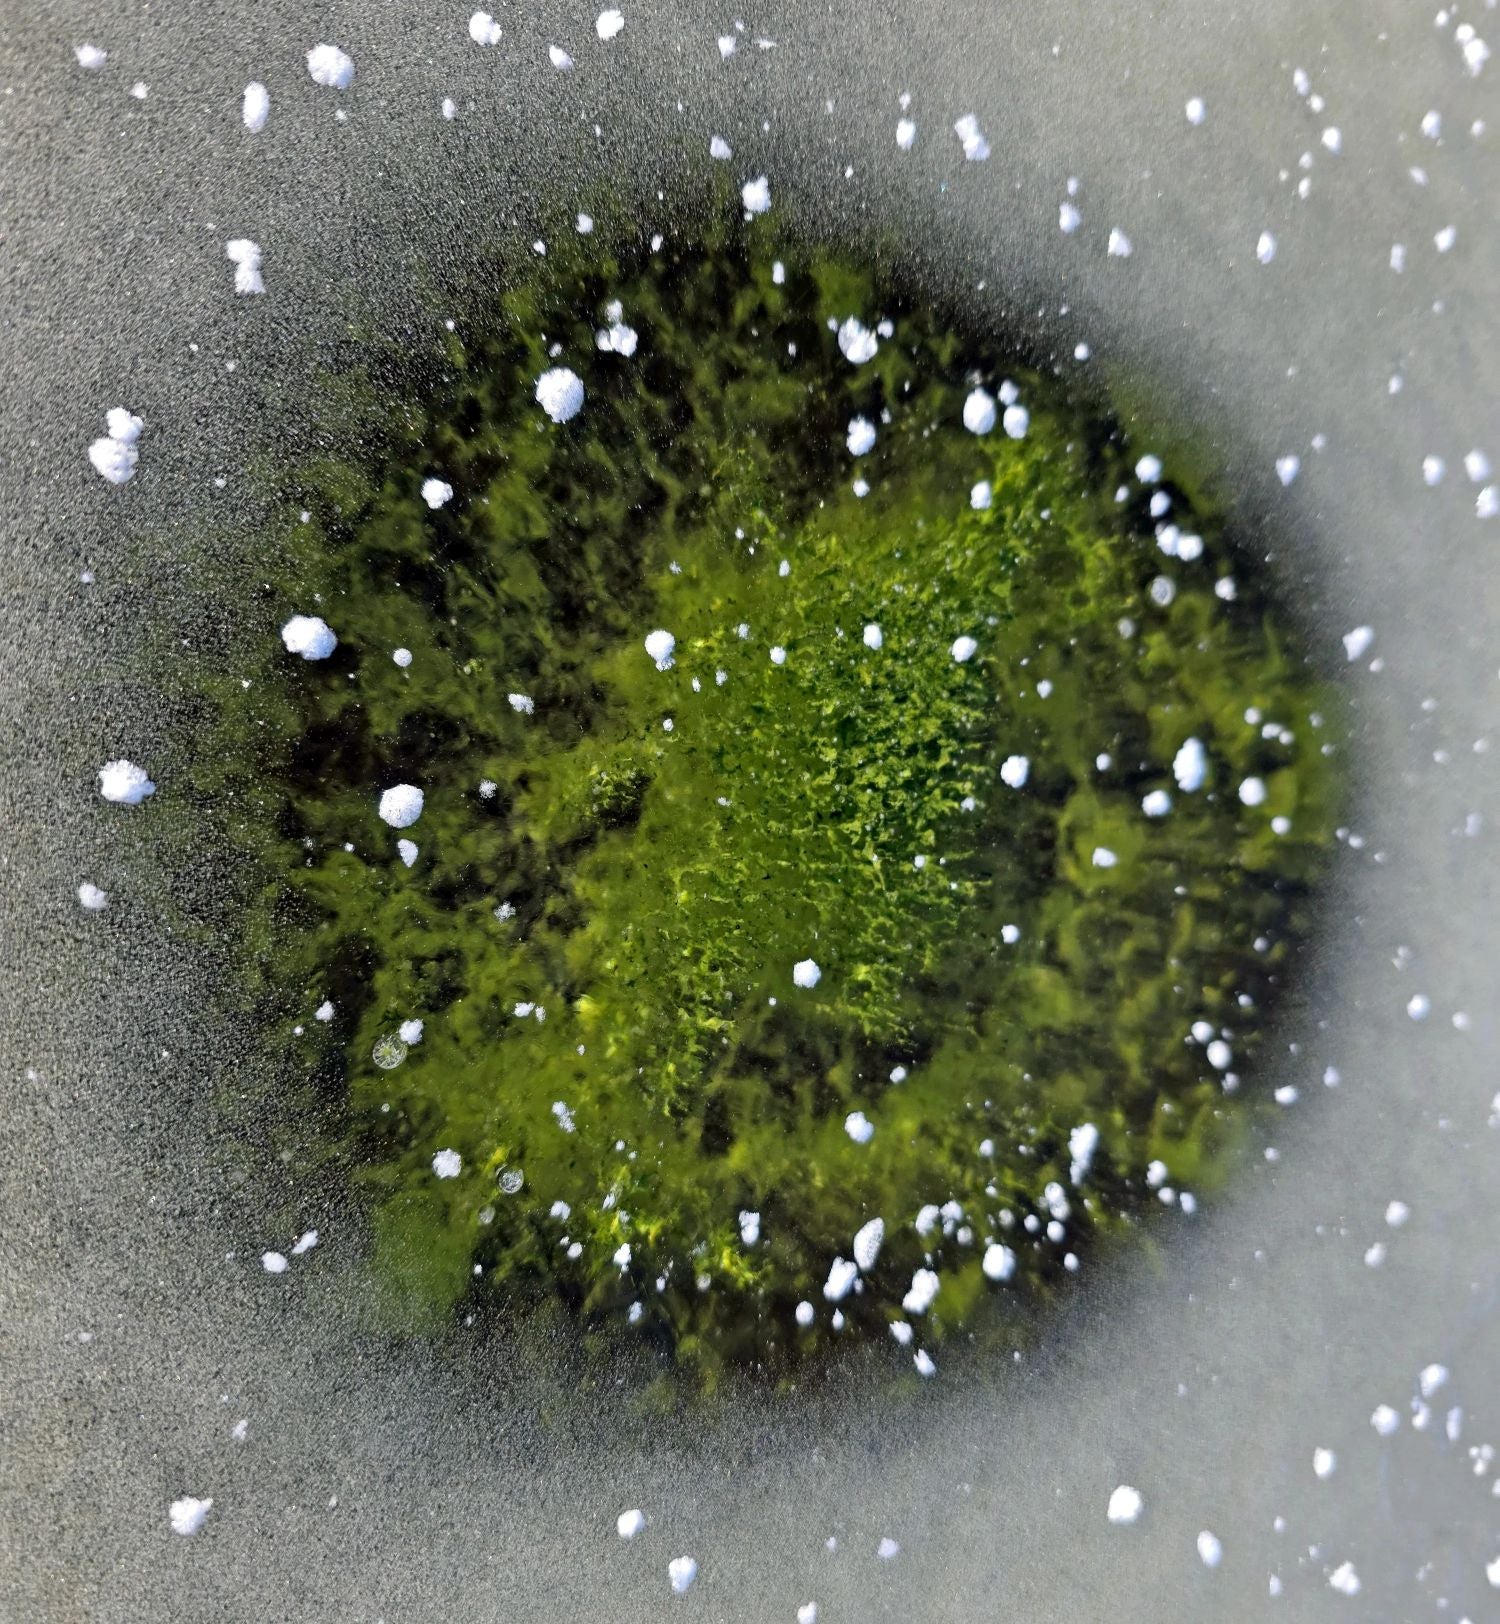

Mundo
Gelo esmeralda cobre barragem na Chéquia: Cientistas explicam o extraordinário fenómeno
Um fenómeno natural invulgar surgiu na barragem de Lipno, no sul da Boémia. No final do ano, uma grande quantidade de cianobactérias acumuladas na água fez com que o gelo ficasse verde

O fenómeno foi documentado em pormenor por hidrobiólogos da Academia das Ciências da Chéquia.
A análise microscópica das amostras confirmou que se trata de uma cianobactéria comum chamada Woronichinia naegeliana. Também aparece em Lipno durante o verão e o outono. A principal causa do crescimento de cianobactérias é o excesso de nutrientes na água, especialmente o fósforo, o que resulta em grande medida da atividade humana.

AV CR / Petr Znachor
Enquanto na maioria das barragens da Chéquia as florescências de cianobactérias desaparecem gradualmente com a chegada do outono e desvanecem-se no final de setembro, Lipno é uma exceção. Os dados a longo prazo mostram que as cianobactérias predominantes até novembro e podem também ocorrer em menor número durante dezembro e janeiro.
Gelo verde
No final de 2025, a biomassa de cianobactérias manteve-se perto da superfície durante um período invulgarmente longo, desde o outono até ao congelamento da albufeira no inverno, provavelmente devido a uma combinação de tempo calmo, ventos fracos e uma longa duração de sol. Sob a fina camada de gelo, por vezes muito transparente, as cianobactérias acumuladas formaram áreas verdes que se destacam, visíveis a partir da costa e de fotografias aéreas.

AV CR / Petr Znachor
O gelo verde foi mais visível durante o período de aquecimento temporário em torno da véspera de Natal e, após o recongelamento, os chamados "olhos de cianobactérias" foram uma caraterística particularmente proeminente, ou seja, áreas de gelo claro acima de aglomerados de cianobactérias escuras que se formaram por absorção diferencial da radiação solar.
O fenómeno persistiu até ao final do ano e só terminou após uma forte queda de neve, que limitou a luz sob o gelo.
"O gelo verde em Lipno enquadra-se nas alterações a longo prazo que estamos a observar aqui, relacionadas com a eutrofização e as alterações climáticas em curso. Isto sugere que poderemos ver mais e mais surpresas como esta no futuro", diz o hidrobiólogo Petr Znachor.
AV CR / Petr Znachor
Até agora, este fenómeno só tinha sido descrito algumas vezes, pelo que a análise intensiva dos cientistas checos significa que o gelo verde de Leiden se tornará um dos casos mais bem descritos do mundo.
De acordo com os especialistas, a situação confirma que a barragem de Lipno tem sido sobrecarregada por um excesso de nutrientes na água, mas também é afetada pelo aquecimento do clima e as mudanças no seu ecossistema estão a ocorrer fora da época tradicional de verão.
Tomáš Karlík / 8 janeiro 2026 10:05 GMT
Edição e Tradução / Joana Bénard da Costa - RTP
Edição e Tradução / Joana Bénard da Costa - RTP
